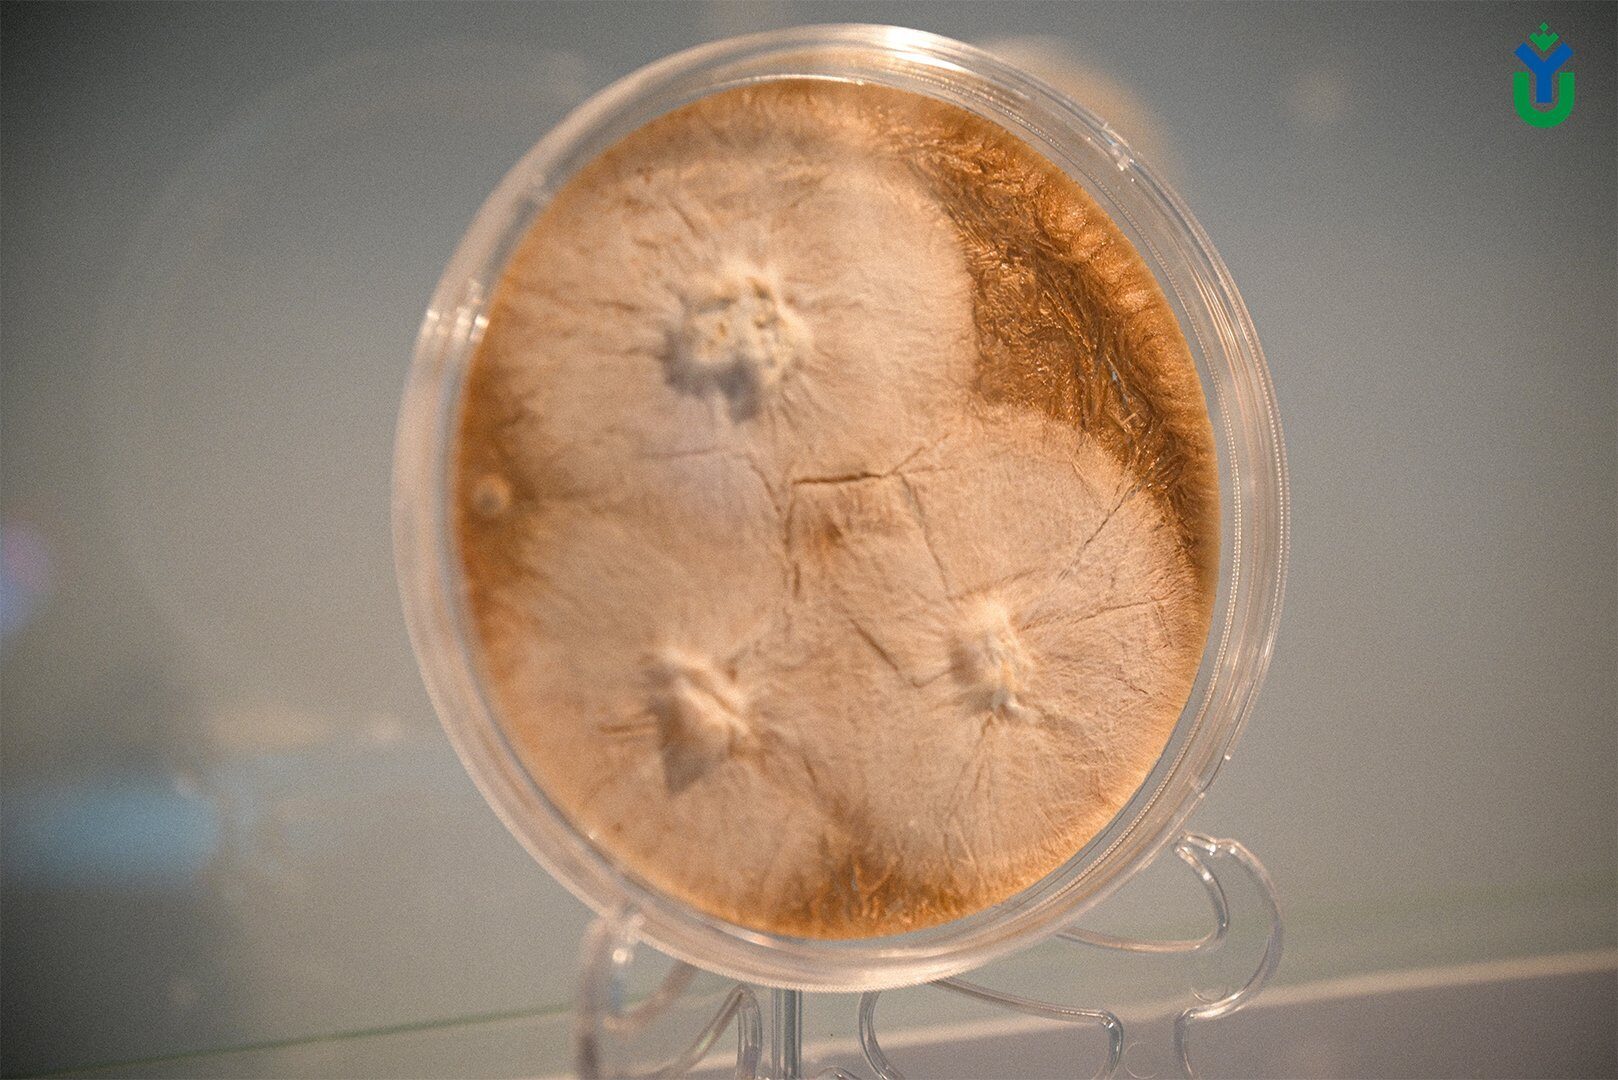

Веб-форма не найдена.
Фонд научно-технологического развития Югры подвел итоги открытого публичного конкурса «Проведение исследований молодежными научными командами под руководством ведущих ученых», который был объявлен 26 ноября. На участие в конкурсе научных проектов поступило 34 заявки от Югорского госуниверситета, СурГУ, СурГПУ, НВГУ, Научно-исследовательского центра им. В.И.Шпильмана, Югорского НИИ информационных технологий, спортивной школы «ЦЦВС» Сургутского района.
По итогам технической и содержательной экспертиз грантами на 2025-2026 гг. поддержаны научные коллективы, объединяющие 25 ведущих ученых и молодых исследователей. В том числе коллектив учёных под руководством заведующей Молекулярно-генетической лабораторией ЮГУ, кандидата биологических наук Нины Филипповой. Нина Владимировна заявила на конкурс разработку микоризных препаратов для увеличения приживаемости древесных пород для биоремедиации и реализации климатических проектов.
«Исследование микоризных грибов и разработка на их основе инновационных биопрепаратов для лесовосстановления в условиях севера Западной Сибири напрямую связаны с приоритетными направлениями развития Югры. Результаты проекта вносят существенный вклад в реализацию Инвестиционной стратегии региона в части развития ЛПК, АПК и перехода к зелёной экономике», - подчеркивает Нина Филиппова.
Как отмечает учёный, микоризные препараты позволят повысить приживаемость саженцев, ускорить рост лесных культур и повысить устойчивость лесов к климатическим изменениям и антропогенным нагрузкам, что в конечном итоге приведет к увеличению лесоресурсного потенциала региона. Использование микоризных технологий способствует реализации углеродной политики региона за счет увеличения приживаемости лесопосадок в климатических проектах, а также увеличения запасов углерода в почве. Восстановление деградированных лесов и создание новых лесных насаждений является одной из ключевых задач современного лесоводства, а также может использоваться как стратегия достижения углеродной нейтральности при реализации проекта экономика климата.
Более того, микоризные грибы в будущем (при расширении технологии) могут быть использованы не только в лесоводстве, но и в сельском хозяйстве, повышая продуктивность сельскохозяйственных культур в условиях Севера.
«Таким образом, результаты проекта не только расширяют наши знания о микоризных сообществах, но и предлагают практические решения для актуальных задач региона, способствуя устойчивому развитию лесопромышленного комплекса, переходу к зеленой экономике и повышению экологической безопасности», - подытожила Нина Владимировна.
Новизна исследования заключается в комплексном подходе, сочетающем традиционные методы микологии с современными молекулярно-генетическими методами. «Мы планируем изучить видовое разнообразие эктомикоризных грибов, связанных с различными древесными породами, создать коллекцию культур микоризных видов, оценить их функциональную активность, и создать микоризные препараты на основе местных штаммов грибов. Результаты данного исследования позволят разработать эффективные технологии лесовосстановления, повысить их устойчивость и скорость роста молодых насаждений», - рассказывают учёные.
Разработать микоризный препарат научный коллектив планирует в течение двух лет. Он будет содержать консорциум штаммов, способный эффективно колонизировать корневую систему различных древесных пород и улучшать их физиологические показатели. Для создания препарата будут использованы современные биотехнологические методы, позволяющие сохранить жизнеспособность спор и мицелия грибов на протяжении длительного времени.
Добавим, что это первое прикладное исследование на базе Фунгария ЮГУ. Благодаря ему и созданной молекулярно-генетической лаборатории вот уже 15 лет ведется накопление данных о разнообразии и экологических функциях грибных организмов на территории севера Западной Сибири. За это время создана коллекция ваучерных образцов, которая включает около 15 тысяч экземпляров, коллекция живых культур, открытый портал данных коллекций, а также долговременные ряды постоянных учетов за микобиотой региона в лесных и болотных ландшафтах, которые ведутся на протяжении 10 лет.
«Организация молодежной молекулярной лаборатории Западно-Сибирского НОЦ мирового уровня дала возможность вывести исследования на новый современный уровень молекулярно-генетических методов, в том числе в области секвенирования второго и третьего поколений и анализа сообществ микроорганизмов методом метабаркодинга», - прокомментировала Нина Филиппова.
Помимо проекта ЮГУ поддержку также получат ещё 4 исследования. Молодежным командам университетов выделят грант в размере 28,5 млн рублей.
По итогам технической и содержательной экспертиз грантами на 2025-2026 гг. поддержаны научные коллективы, объединяющие 25 ведущих ученых и молодых исследователей. В том числе коллектив учёных под руководством заведующей Молекулярно-генетической лабораторией ЮГУ, кандидата биологических наук Нины Филипповой. Нина Владимировна заявила на конкурс разработку микоризных препаратов для увеличения приживаемости древесных пород для биоремедиации и реализации климатических проектов.
«Исследование микоризных грибов и разработка на их основе инновационных биопрепаратов для лесовосстановления в условиях севера Западной Сибири напрямую связаны с приоритетными направлениями развития Югры. Результаты проекта вносят существенный вклад в реализацию Инвестиционной стратегии региона в части развития ЛПК, АПК и перехода к зелёной экономике», - подчеркивает Нина Филиппова.
Как отмечает учёный, микоризные препараты позволят повысить приживаемость саженцев, ускорить рост лесных культур и повысить устойчивость лесов к климатическим изменениям и антропогенным нагрузкам, что в конечном итоге приведет к увеличению лесоресурсного потенциала региона. Использование микоризных технологий способствует реализации углеродной политики региона за счет увеличения приживаемости лесопосадок в климатических проектах, а также увеличения запасов углерода в почве. Восстановление деградированных лесов и создание новых лесных насаждений является одной из ключевых задач современного лесоводства, а также может использоваться как стратегия достижения углеродной нейтральности при реализации проекта экономика климата.
Более того, микоризные грибы в будущем (при расширении технологии) могут быть использованы не только в лесоводстве, но и в сельском хозяйстве, повышая продуктивность сельскохозяйственных культур в условиях Севера.
«Таким образом, результаты проекта не только расширяют наши знания о микоризных сообществах, но и предлагают практические решения для актуальных задач региона, способствуя устойчивому развитию лесопромышленного комплекса, переходу к зеленой экономике и повышению экологической безопасности», - подытожила Нина Владимировна.
Новизна исследования заключается в комплексном подходе, сочетающем традиционные методы микологии с современными молекулярно-генетическими методами. «Мы планируем изучить видовое разнообразие эктомикоризных грибов, связанных с различными древесными породами, создать коллекцию культур микоризных видов, оценить их функциональную активность, и создать микоризные препараты на основе местных штаммов грибов. Результаты данного исследования позволят разработать эффективные технологии лесовосстановления, повысить их устойчивость и скорость роста молодых насаждений», - рассказывают учёные.
Разработать микоризный препарат научный коллектив планирует в течение двух лет. Он будет содержать консорциум штаммов, способный эффективно колонизировать корневую систему различных древесных пород и улучшать их физиологические показатели. Для создания препарата будут использованы современные биотехнологические методы, позволяющие сохранить жизнеспособность спор и мицелия грибов на протяжении длительного времени.
Добавим, что это первое прикладное исследование на базе Фунгария ЮГУ. Благодаря ему и созданной молекулярно-генетической лаборатории вот уже 15 лет ведется накопление данных о разнообразии и экологических функциях грибных организмов на территории севера Западной Сибири. За это время создана коллекция ваучерных образцов, которая включает около 15 тысяч экземпляров, коллекция живых культур, открытый портал данных коллекций, а также долговременные ряды постоянных учетов за микобиотой региона в лесных и болотных ландшафтах, которые ведутся на протяжении 10 лет.
«Организация молодежной молекулярной лаборатории Западно-Сибирского НОЦ мирового уровня дала возможность вывести исследования на новый современный уровень молекулярно-генетических методов, в том числе в области секвенирования второго и третьего поколений и анализа сообществ микроорганизмов методом метабаркодинга», - прокомментировала Нина Филиппова.
Помимо проекта ЮГУ поддержку также получат ещё 4 исследования. Молодежным командам университетов выделят грант в размере 28,5 млн рублей.
Дата:
25.12.2024